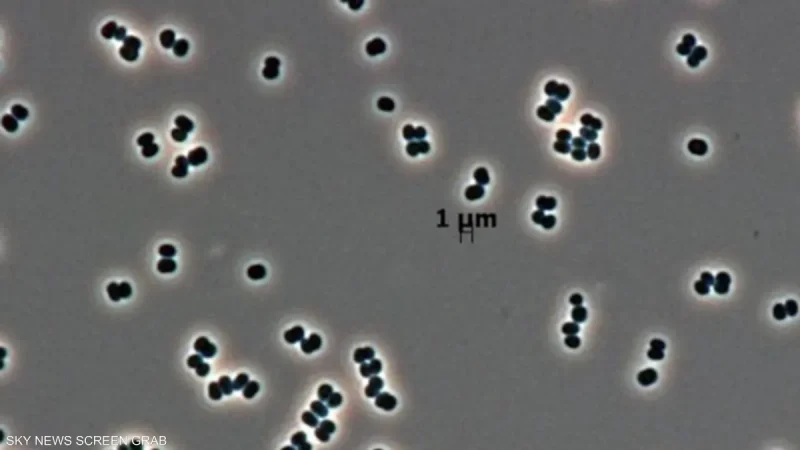
بكتيريا

كشفت دراسة حديثة أن وكالة “ناسا” عثرت على نوع بكتيري نادر يمتلك قدرة فريدة على الدخول في حالة خمول عميقة تجعله غير قابل للكشف تقريباً، ما يثير احتمالاً بأن يكون قد انتقل بالصدفة إلى المريخ على متن مركبات فضائية.
البكتيريا الجديدة، التي أُطلق عليها Tersicoccus phoenicis، اكتُشفت قبل نحو عقد داخل غرف التعقيم الخاصة بتجميع المركبات الفضائية في ناسا ووكالة الفضاء الأوروبية، رغم أن هذه الغرف تُعدّ من أنظف البيئات على سطح الأرض والمخصصة لمنع انتقال أي ميكروبات إلى الكواكب الأخرى.
ورغم أنها غير مؤذية، فإن قدرتها على النجاة في أقسى الظروف أثارت قلق العلماء، خاصة بعد تكرار ظهورها في منشأتين تفصل بينهما آلاف الكيلومترات.
الدراسة كشفت أن هذه البكتيريا قادرة على الدخول في سبات شبه كامل يمنع العلماء من رصدها أو تنميتها مخبرياً.